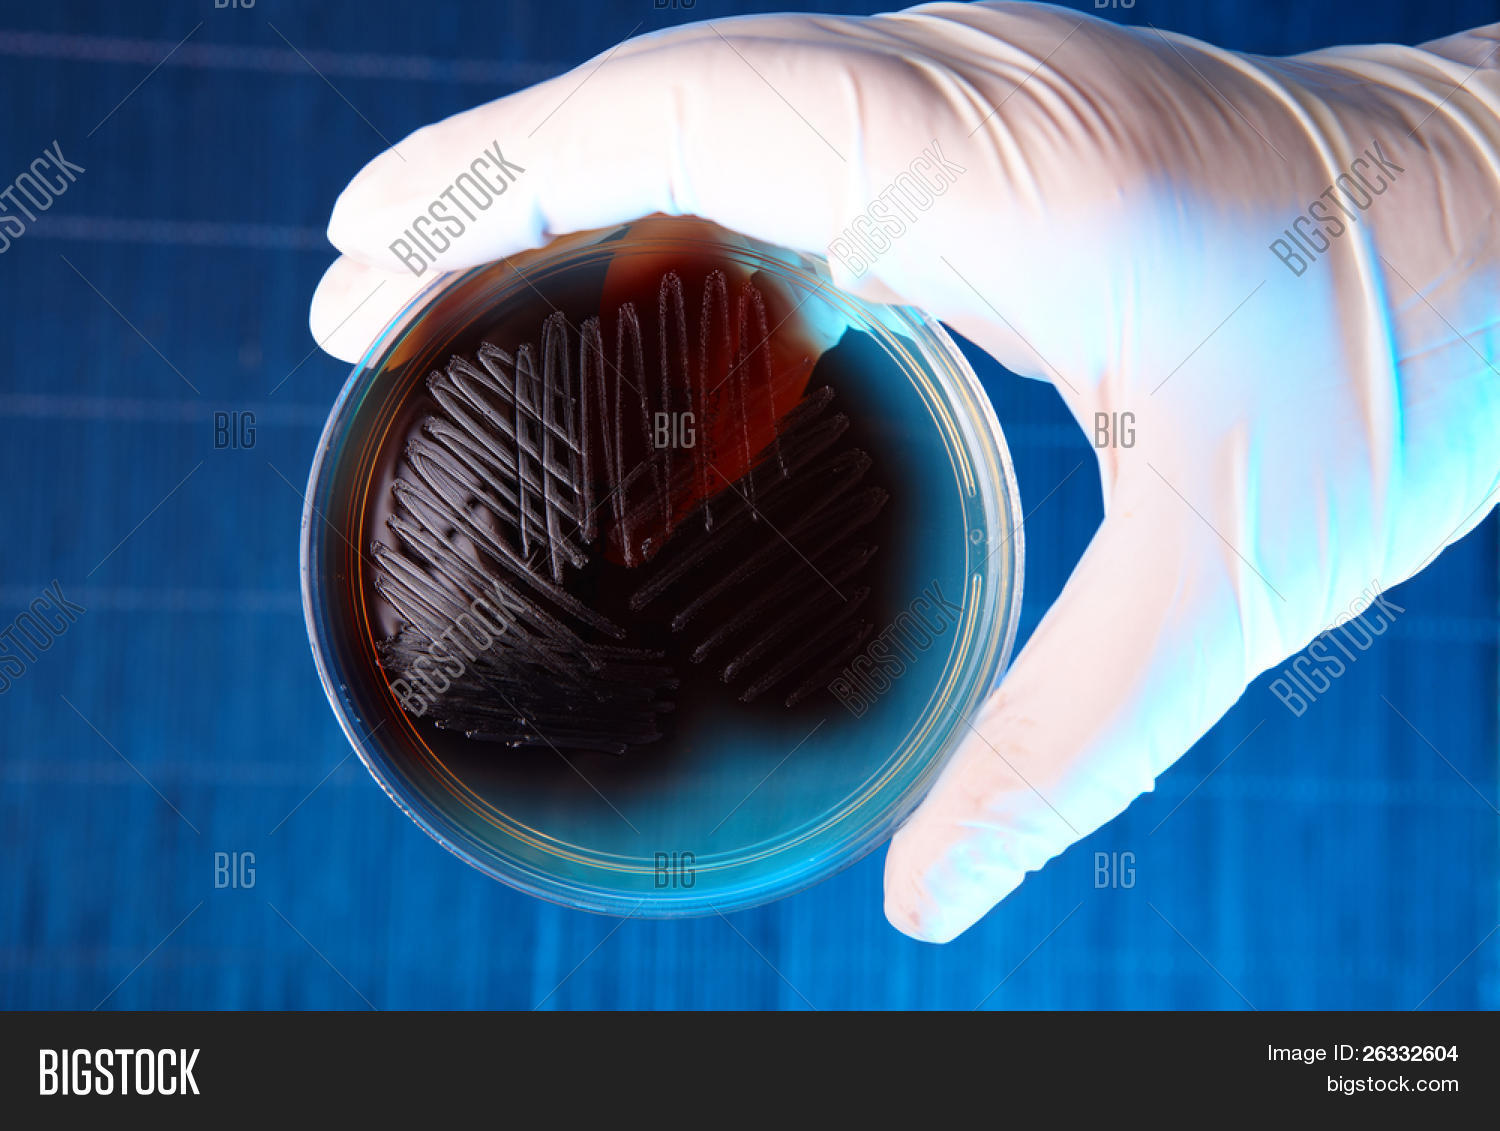

терококк 3 10 3
Энтерококк 3 10 3 109 фото
Приманка narval skinny
Петронас сайт
Прокладки kotex супер
Медаль 50 лет баму какие льготы
Какой телефон лучше брать в 2026 году
Кофемашина proliss инструкция
Погода в кунгуре карта осадков на сегодня
Семья рогожина
Подключение по rtsp trassir
Как установить моды на half life 2